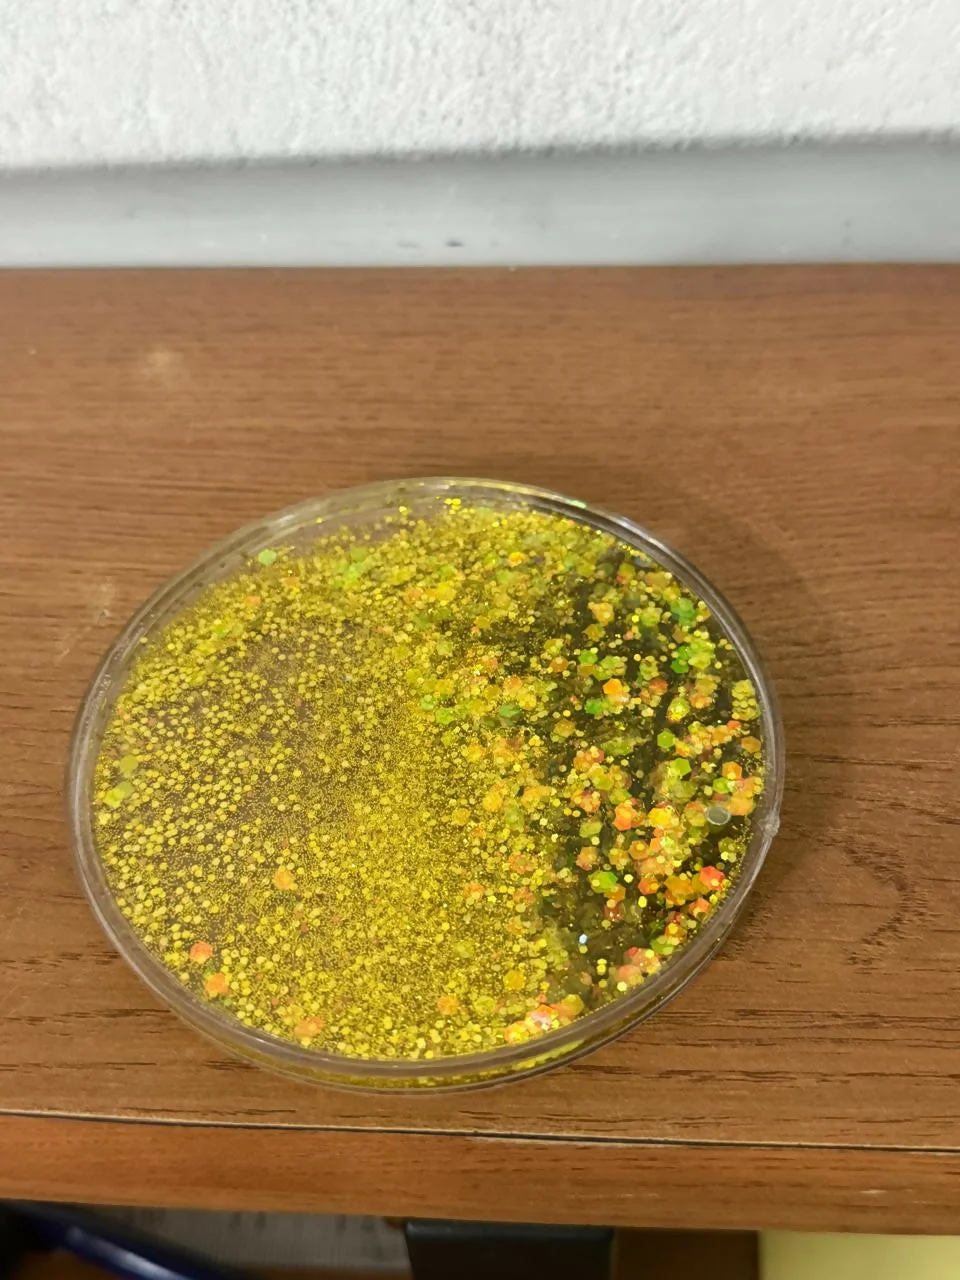

Free shipping on orders above Rs.999!

Free Shipping
Above ₹999
100% Genuine
Authentic
Easy Returns
7-day policy
Fast Delivery
2–5 business days
Add a touch of sparkle to your coffee or tea time with this premium glitter resin tea coaster. Designed to protect your table from heat marks, spills, and scratches, this round coaster combines functionality with eye-catching style. The smooth resin finish with embedded glitter gives a modern, elegant look that enhances any dining table, office desk, or bedside setup. Ideal for daily use and gifting.
Premium Resin Material: Strong, durable, and long-lasting with a glossy finish
Heat & Spill Protection: Protects surfaces from hot cups, moisture, and stains
Anti-Slip Base: Stays firmly in place on tables and countertops
Elegant Glitter Design: Stylish sparkle enhances home and office décor
Easy to Clean: Simply wipe with a damp cloth for quick maintenance
Multi-Purpose Use: Suitable for tea cups, coffee mugs, glasses, and tumblers
Shape: Round
Material: Resin
Finish: Glossy with embedded glitter
Use: Table protection, home décor, office desk accessory
glitter tea coaster, resin cup coaster, table coaster for mugs, coffee coaster, tea cup stand, round coaster, glitter coaster for table, resin coaster set, anti slip coaster, heat resistant coaster, home décor coaster, office desk coaster
You might also like

₹54
Save ₹54
Be the first to review Golden Glitter Resin Tea Coaster for Cups & Mugs ( MUG NOT INCLUDED)!
No account needed — verify with OTP
0/1000
We'll verify your identity with a quick OTP